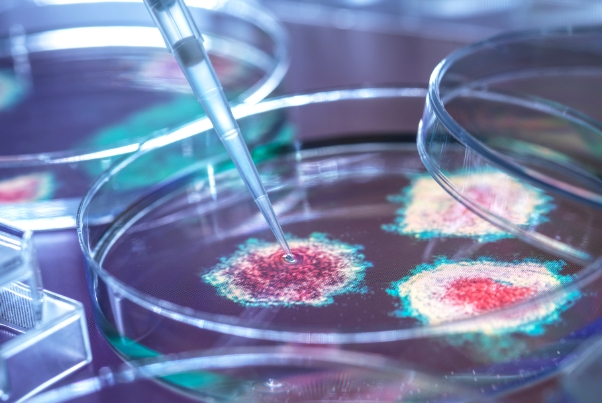

早上八点的生殖医学中心候诊室里,李女士攥着检查单的手微微发抖。38岁的她已经历三次试管失败,医生建议尝试三代试管婴儿技术。「他们说能筛掉染色体问题,可这新技术真的安全吗?」她的疑问道出了许多求子家庭的心声。
这项全称为「胚胎植入前遗传学检测」的技术,确实让染色体异常导致的流产率从60%降至15%以下。但就像打开潘多拉魔盒,2023年《人类生殖医学》期刊数据显示,使用三代试管的活产率仅比传统试管高出8%,而医疗风险却增加了近三成。
一、那些藏在数据里的健康警报
促排卵药物引发的卵巢过度刺激综合征(OHSS),在三代试管群体中发生率高达12%。32岁的张薇至今记得取卵后腹胀如鼓的煎熬:「肚子鼓得像怀孕六个月,连呼吸都困难。」更棘手的是,胚胎活检时1-2%的损伤率看似不高,但对于仅获得1-2个优质胚胎的家庭而言,这个概率足以让人彻夜难眠。
「我们接诊过活检后胚胎停止发育的案例。」北京某三甲医院生殖科主任王建华坦言。而多胎妊娠这个「甜蜜的负担」更需警惕——为提高成功率植入多个胚胎,导致30%的三代试管妈妈面临早产、妊娠高血压等风险。
二、心理过山车与钱包缩水记
在知乎「试管婴儿」话题下,超过2万条讨论诉说着情绪波动。28岁的程序员小林晒出记账本:三代试管平均8-15万的花费,相当于他整整两年的积蓄。「每次收到『胚胎筛查未通过』的短信,就像往碎钞机里又扔了几万块。」
更隐秘的是伦理困境。某省会城市2022年的调查显示,65%的夫妻会纠结「该不该淘汰携带遗传病基因但可能不发病的胚胎」。生命伦理学教授赵明辉指出:「我们正在模糊治疗与优化的界限。」
三、聪明应对风险指南
选择有PGT资质的正规医院至关重要——目前全国仅83家医疗机构通过认证。心理专家建议建立支持小组,广州某生殖中心的数据显示,参与心理干预的夫妻成功率提升17%。财务方面可以考虑分期付款,部分保险已开始覆盖试管费用。
「技术就像双刃剑,」从事辅助生殖20年的李主任说,「去年我们帮助512对夫妻圆梦,但也有37例因风险放弃。」随着基因编辑等新技术加入,如何在希望与风险间找到平衡点,考验着每个求子家庭的智慧。
当诊室叫号声再次响起,李女士整了整衣角走向诊室。或许正如《柳叶刀》那篇社论所说:「生殖医学的终极课题,不是突破技术极限,而是守护生命尊严。」这条路注定不易,但至少,我们可以选择清醒地前行。

